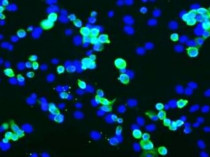

ARG42919
anti-SARS-CoV / SARS-CoV-2 nucleocapsid protein antibody
anti-SARS-CoV / SARS-CoV-2 nucleocapsid protein antibody for ICC/IF,Western blot and Virus
概述
| 产品描述 | Rabbit Polyclonal antibody recognizes nucleocapsid protein |
|---|---|
| 反应物种 | Virus |
| 应用 | ICC/IF, WB |
| 宿主 | Rabbit |
| 克隆 | Polyclonal |
| 同位型 | IgG |
| 靶点名称 | SARS-CoV / SARS-CoV-2 nucleocapsid protein |
| 抗原物种 | Virus |
| 抗原 | SARS-CoV / SARS-CoV-2 nucleocapsid protein |
| 偶联标记 | Un-conjugated |
应用说明
| 应用建议 |
|
||||||
|---|---|---|---|---|---|---|---|
| 应用说明 | * The dilutions indicate recommended starting dilutions and the optimal dilutions or concentrations should be determined by the scientist. |
属性
| 形式 | Liquid |
|---|---|
| 纯化 | Affinity purification. |
| 缓冲液 | 100 mM Tris Glycine (pH 7.0), 0.025% Proclin 300 and 20% Glycerol. |
| 抗菌剂 | 0.025% Proclin 300 |
| 稳定剂 | 20% Glycerol |
| 浓度 | 0.43 mg/ml |
| 存放说明 | For continuous use, store undiluted antibody at 2-8°C for up to a week. For long-term storage, aliquot and store at -20°C. Storage in frost free freezers is not recommended. Avoid repeated freeze/thaw cycles. Suggest spin the vial prior to opening. The antibody solution should be gently mixed before use. |
| 注意事项 | For laboratory research only, not for drug, diagnostic or other use. |
生物信息
| 产品亮点 | Related products: SARS-CoV antibodies; SARS-CoV ELISA Kits; SARS-CoV recombinant proteins; Anti-Rabbit IgG secondary antibodies; Related news: HMGB1, a biomarker and therapeutic target in COVID-19 |
|---|
检测图片 (2) Click the Picture to Zoom In
-
ARG42919 anti-SARS-CoV / SARS-CoV-2 nucleocapsid protein antibody ICC/IF image
Immunofluorescence: SARS-CoV-2 infected cells were stained with ARG42919 anti-SARS-CoV / SARS-CoV-2 nucleocapsid protein antibody (green) at 1:500 dilution and 4°C. DAPI (blue) for nuclear staining.
-
ARG42919 anti-SARS-CoV / SARS-CoV-2 nucleocapsid protein antibody WB image
Western blot: SARS-CoV-2 infected (left) and uninfected (right) VeroE6 cells. 30 ug of cell lysates were stained with ARG42919 anti-SARS-CoV / SARS-CoV-2 nucleocapsid protein antibody at 1:3000 dilution.